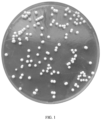

EP4530342A1 - Hefestamm für schnellfermentierenden zuckerfreien teig und verwendung davon - Google Patents
Hefestamm für schnellfermentierenden zuckerfreien teig und verwendung davon Download PDFInfo
- Publication number
- EP4530342A1 EP4530342A1 EP23810585.2A EP23810585A EP4530342A1 EP 4530342 A1 EP4530342 A1 EP 4530342A1 EP 23810585 A EP23810585 A EP 23810585A EP 4530342 A1 EP4530342 A1 EP 4530342A1
- Authority
- EP
- European Patent Office
- Prior art keywords
- saccharomyces cerevisiae
- strain
- dough
- amcc31248
- yeast
- Prior art date
- Legal status (The legal status is an assumption and is not a legal conclusion. Google has not performed a legal analysis and makes no representation as to the accuracy of the status listed.)
- Pending
Links
Images
Classifications
-
- A—HUMAN NECESSITIES
- A21—BAKING; EDIBLE DOUGHS
- A21D—TREATMENT OF FLOUR OR DOUGH FOR BAKING, e.g. BY ADDITION OF MATERIALS; BAKING; BAKERY PRODUCTS
- A21D8/00—Methods for preparing or baking dough
- A21D8/02—Methods for preparing dough; Treating dough prior to baking
- A21D8/04—Methods for preparing dough; Treating dough prior to baking treating dough with microorganisms or enzymes
- A21D8/047—Methods for preparing dough; Treating dough prior to baking treating dough with microorganisms or enzymes with yeasts
-
- A—HUMAN NECESSITIES
- A21—BAKING; EDIBLE DOUGHS
- A21D—TREATMENT OF FLOUR OR DOUGH FOR BAKING, e.g. BY ADDITION OF MATERIALS; BAKING; BAKERY PRODUCTS
- A21D13/00—Finished or partly finished bakery products
- A21D13/06—Products with modified nutritive value, e.g. with modified starch content
- A21D13/062—Products with modified nutritive value, e.g. with modified starch content with modified sugar content; Sugar-free products
-
- A—HUMAN NECESSITIES
- A21—BAKING; EDIBLE DOUGHS
- A21D—TREATMENT OF FLOUR OR DOUGH FOR BAKING, e.g. BY ADDITION OF MATERIALS; BAKING; BAKERY PRODUCTS
- A21D8/00—Methods for preparing or baking dough
- A21D8/02—Methods for preparing dough; Treating dough prior to baking
- A21D8/04—Methods for preparing dough; Treating dough prior to baking treating dough with microorganisms or enzymes
-
- C—CHEMISTRY; METALLURGY
- C12—BIOCHEMISTRY; BEER; SPIRITS; WINE; VINEGAR; MICROBIOLOGY; ENZYMOLOGY; MUTATION OR GENETIC ENGINEERING
- C12N—MICROORGANISMS OR ENZYMES; COMPOSITIONS THEREOF; PROPAGATING, PRESERVING, OR MAINTAINING MICROORGANISMS; MUTATION OR GENETIC ENGINEERING; CULTURE MEDIA
- C12N1/00—Microorganisms; Compositions thereof; Processes of propagating, maintaining or preserving microorganisms or compositions thereof; Processes of preparing or isolating a composition containing a microorganism; Culture media therefor
- C12N1/14—Fungi; Culture media therefor
- C12N1/16—Yeasts; Culture media therefor
- C12N1/18—Baker's yeast; Brewer's yeast
- C12N1/185—Saccharomyces isolates
-
- C—CHEMISTRY; METALLURGY
- C12—BIOCHEMISTRY; BEER; SPIRITS; WINE; VINEGAR; MICROBIOLOGY; ENZYMOLOGY; MUTATION OR GENETIC ENGINEERING
- C12R—INDEXING SCHEME ASSOCIATED WITH SUBCLASSES C12C - C12Q, RELATING TO MICROORGANISMS
- C12R2001/00—Microorganisms ; Processes using microorganisms
- C12R2001/645—Fungi ; Processes using fungi
- C12R2001/85—Saccharomyces
- C12R2001/865—Saccharomyces cerevisiae
-
- Y—GENERAL TAGGING OF NEW TECHNOLOGICAL DEVELOPMENTS; GENERAL TAGGING OF CROSS-SECTIONAL TECHNOLOGIES SPANNING OVER SEVERAL SECTIONS OF THE IPC; TECHNICAL SUBJECTS COVERED BY FORMER USPC CROSS-REFERENCE ART COLLECTIONS [XRACs] AND DIGESTS
- Y02—TECHNOLOGIES OR APPLICATIONS FOR MITIGATION OR ADAPTATION AGAINST CLIMATE CHANGE
- Y02E—REDUCTION OF GREENHOUSE GAS [GHG] EMISSIONS, RELATED TO ENERGY GENERATION, TRANSMISSION OR DISTRIBUTION
- Y02E50/00—Technologies for the production of fuel of non-fossil origin
- Y02E50/10—Biofuels, e.g. bio-diesel
Definitions
- the present invention relates to the field of microorganisms and in particular to a yeast strain for fast-fermenting sugar-free dough and use thereof.
- the dough fermentation process always plays a crucial role, not only affecting the flour product softness, taste, nutritional value, etc. but also determining the speed of the dough leavening.
- the temperature of the environment is often too high, which causes the yeast to start too fast during kneading dough and causes the quality of the product to decline.
- low-temperature water is usually added to reduce the temperature, but the yeast cells will enter into a shock state when they encounter a low-temperature environment, thus affecting the normal growth of yeast cells. There is therefore an urgent need for cold osmotic shock resistance of yeast.
- the present invention provides a yeast strain for fast-fermenting sugar-free dough with cold osmotic shock resistance.
- the present invention provides a Saccharomyces cerevisiae strain comprising: Saccharomyces cerevisiae AMCC31248 strain (Saccharomyces cerevisiae AMCC31248) deposited at the China Center for Type Culture Collection (CCTCC) with the deposit number CCTCC NO: M 20211686.
- the present invention provides a fermentative preparation method for a Saccharomyces cerevisiae microbial agent, the process comprising the following steps: culturing the Saccharomyces cerevisiae strain.
- the preparation method comprises the following steps:
- the present invention provides a microbial agent containing the strain of Saccharomyces cerevisiae AMCC31248 strain (Saccharomyces cerevisiae AMCC31248).
- the microbial agent is obtained by the fermentative preparation method.
- the present invention also provides the use of the Saccharomyces cerevisiae strain or the microbial agent in fermentation.
- the present invention also provides the use of the microbial agent of the Saccharomyces cerevisiae strain in a dough.
- the present invention provides a dough containing the Saccharomyces cerevisiae strain or the microbial agent.
- the dough contains flour and the Saccharomyces cerevisiae strain in a mass ratio of 100:0.5-5.
- the present invention also provides a preparation method for a dough comprising the following steps: kneading the dough with water at 0-35°C.
- the water at 0°C in the present invention may be ice at 0°C or a mixture of ice and water at 0°C or liquid water at 0°C.
- the water, the flour, and the Saccharomyces cerevisiae may be added in any order, such as mixing the flour and the Saccharomyces cerevisiae and then adding water at 0-35°C for kneading dough, adding the flour to water at 0-35°C and then adding the Saccharomyces cerevisiae, or adding the Saccharomyces cerevisiae to water at 0-35°C and then adding the flour.
- the present invention also provides a flour product obtainable by the dough preparation method.
- the flour product is a steamed bread, a steamed stuffed bun, a bread, a biscuit, a noodle, a pan-fried dumpling, and the like.
- the present invention provides Saccharomyces cerevisiae AMCC31248 strain (Saccharomyces cerevisiae AMCC31248) provided by the present invention has good fermentation performance in sugar-free dough, can ferment sugar-free dough rapidly, and has good cold osmotic shock resistance.
- Saccharomyces cerevisiae AMCC31248 strain (Saccharomyces cerevisiae AMCC31248) provided by the present invention was deposited at the China Center for Type Culture Collection (CCTCC) on December 29, 2021, under the deposit number CCTCC NO: M 20211686, deposited at Wuhan University, Wuhan, China, postal code: 430072; TEL: 027-68754052.
- Saccharomyces cerevisiae AMCC30010 strain (Saccharomyces cerevisiae AMCC30010) used in the present invention was deposited at the China Center for Type Culture Collection (CCTCC) on March 29, 2022, under the deposit number CCTCC NO: M 2022340, deposited at Wuhan University, Wuhan, China, postal code: 430072; TEL: 027-68754052.
- Saccharomyces cerevisiae AMCC32101 strain (Saccharomyces cerevisiae AMCC32101) provided by the present invention was deposited at the China Center for Type Culture Collection (CCTCC) on March 29, 2022, with the deposit number CCTCC NO: M 2022341, deposited at Wuhan University, Wuhan, China, postal code: 430072; TEL: 027-68754052.
- a Saccharomyces cerevisiae AMCC31248 strain provided by the present invention is obtained by a micro hybridization method using a Saccharomyces cerevisiae AMCC30010 strain and a Saccharomyces cerevisiae AMCC32101 strain as parents.
- Saccharomyces cerevisiae AMCC30010 (Saccharomyces cerevisiae AMCC30010) strain is a Saccharomyces cerevisiae strain bred by Angel Yeast Co. Ltd. which was collected from Yichang City, Hubei province.
- the cell morphology of the Saccharomyces cerevisiae strain was observed by light microscopy to be oval, budding, and a single colony growing on a solid plate with a slightly raised central spherical shape, milky white, smooth surface, and neat edge. Morphological observation and molecular biological identification by high-power microscope confirmed that it is a strain of Saccharomyces cerevisiae, which is a food product attribute. It was deposited with the China Center for Type Culture Collection (CCTCC) on March 29, 2022, with the deposit number CCTCC NO: M 2022340 (i.e. CCTCC M 2022340).
- CCTCC NO: M 2022340 deposit number
- Saccharomyces cerevisiae AMCC32101 (Saccharomyces cerevisiae AMCC32101) strain is a Saccharomyces cerevisiae strain bred by Angel Yeast Co. Ltd. which was collected from the city of Ulanqab, Inner Mongolia Autonomous Region. The cell morphology of the Saccharomyces cerevisiae strain was observed by light microscopy to be oval, budding, and a single colony growing on a solid plate with a slightly raised central spherical shape, milky white, smooth surface, and neat edge. Morphological observation and molecular biological identification by high-power microscope confirmed that it is a strain of Saccharomyces cerevisiae, which is a food product attribute. It was deposited with the China Center for Type Culture Collection (CCTCC) on March 29, 2022, with the deposit number CCTCC NO: M 2022341 (i.e. CCTCC M 2022341).
- CCTCC NO: M 2022341 i.e
- the strain of Saccharomyces cerevisiae AMCC31248 strain provided by the present invention has good fermentation performance in sugar-free dough and can ferment sugar-free dough rapidly.
- Some sugar-free bread, soda biscuits, and steamed bread are mainly made by sugar-free dough fermentation.
- Most of the flour is starch, which is converted into maltose under the action of amylase in flour. Therefore, the maltose utilization ability of yeast determines the rising speed of sugar-free dough.
- the maltose utilization enzymes of yeast include maltase and maltose permease. The yeast with high maltose utilization ability is called fast-fermenting yeast.
- Sugar-tolerant yeast means that it has a higher tolerance to sucrose in sugar-containing doughs, i.e. the growth and fermentation properties in sugar-containing breads are higher than in normal yeasts.
- Low sugar tolerant yeasts are used in about 7% sucrose dough systems, and high sugar tolerant yeasts are used in higher sucrose concentration dough systems, up to 25%.
- Sucrose is generally not directly available to microorganisms, whereas Saccharomyces cerevisiae contains a sucrose hydrolyzing enzyme that degrades sucrose, which acts on the beta -1,2 glycosidic linkages to hydrolyze sucrose to D-glucose and D-fructose, which then enters the glycolytic pathway for use by the yeast, while the glucose and fructose produced by the rapid decomposition of sucrose increase the osmotic pressure around the yeast cells.
- the yeast cell membrane is a selective semi-permeable biofilm.
- the activity of yeast cells is affected by the concentration of the external environment.
- the water content and protoplast in the cells will leak out of the cell membrane to make the cells dehydrated and even die. Therefore, the high osmotic environment that Saccharomyces cerevisiae faces in high-sugar dough has an effect on its growth and fermentation performance. Therefore, the gas production capacity of sugar-free yeast is determined by maltose utilization enzyme activity, and the gas production capacity of sugar-tolerant yeast is determined by sucrase activity.
- Table 1 Reagents information table Reagents Vendor Yeast extract powder Angel yeast Peptone Angel yeast Glucose SCR, SINOPHARM Agar Huixing Potassium acetate SCR, SINOPHARM Table 2 Instrument information sheet Instrument Model Vendor Constant temperature shaker ZWYR-2102C Shanghai Zhicheng Biochemical incubator SPX-150BIII Tianjin Taiste Bechtop SKJH-1109 Shanghai Sukun Clean bench ME4002E METTLER TOLEDO pH meter PB-10 Sartorius Thermostat water bath HH-2 Jiangsu Guohua Centrifuge DL-5200B Shanghai Anting Rapid moisture meter MJ33 METTLER TOLEDO PCR instrument C1000 BIO-RAD Gel imaging system Gel Doc TM XR + BIO-RAD Electrophoresis apparatus EPS-300 Shanghai Tianneng Light microscope CX43 OLYMPUS Fully automatic growth curve analyzer Bioscreen
- the formulation of the sporulation medium used in the examples of the present invention was: 1% potassium acetate, 0.1% yeast extract powder, 0.05% glucose, and 2% agar.
- each Saccharomyces cerevisiae strain was activated using a YPD solid medium
- the formulation of the YPD solid medium was as follows: 1% yeast extract powder, 2% peptone, 2% glucose, and 2% agar.
- each Saccharomyces cerevisiae strain was cultured in a YPD liquid medium: the formulation of the YPD liquid medium was as follows: 1% yeast extract powder, 2% peptone, and 2% glucose.
- the parent strains Saccharomyces cerevisiae AMCC30010 strain and Saccharomyces cerevisiae AMCC32101 strain were activated and induced to sporulate, respectively. After the enzymolysis of bacterial cells, the single spores were picked using a yeast micromanipulator, and the single spores from two different parents were contacted, and then cultured at 30°C. The spore morphology was observed, and the strain was continued to incubate at 30°C after two single spores were successfully hybridized. This was a first-generation strain. The first-generation strains were further crossed with the Saccharomyces cerevisiae AMCC30010 strain to obtain the second-generation strains, which were then tested for sporulation, and heterozygous strains were selected for subsequent screening.
- the growth curve of the new heterozygous strains was determined by the fully automatic growth curve analyzer Bioscreen C, and the heterozygous strains with higher growth efficiency than their parents and ranked first 20 were selected.
- a shake flask fermentation test was performed on 20 heterozygous strains with higher growth efficiency than their parents.
- the net dry weight of the strain and the fermentation activity of fresh yeast in the 0% sugar dough system were used as screening indicators, heterozygous strains with net dry weight of yeast milk reaching 95-105% of either parent and 0% sugar dough fermentation activity reaching 95%-150% of either parent were selected.
- the heterozygous strains obtained by the above-mentioned screening step were cultured in a 45 L fermenter system, and the obtained yeast cells were respectively prepared into active dry yeasts, and the fermentation activity of the active dry yeasts in a 0% sugar dough system was determined, and a new strain was selected which has no obvious abnormality during the preparation of the dry yeasts, and the 0% sugar dough fermentation activity of the active dry yeasts can reach 95%-120% of that of any parent.
- heterozygous strains preferred in the above-mentioned steps were screened for cold osmotic shock resistance.
- 0% sugar dough containing heterozygous strain active dry yeast was prepared with crushed ice and flour at 0°C by kneading dough, and the leavening time of the dough was determined.
- the heterozygous strain with the shortest leavening time of the corresponding dough was used as the target strain to screen out the heterozygous strain with cold osmotic shock resistance.
- a heterozygous strain named AMCC31248 was obtained by the above-mentioned screening, which had high fermentation activity in 0% sugar dough and good cold osmotic shock resistance. The strain was identified and the identification result was:
- the resulting heterozygous strain AMCC31248 was named Saccharomyces cerevisiae AMCC31248 strain (Saccharomyces cerevisiae AMCC31248). This Saccharomyces cerevisiae strain AMCC31248 was deposited at the China Center for Type Culture Collection (CCTCC) on December 29, 2021, with the deposit number CCTCC NO: M 20211686 (i.e. CCTCC M 20211686).
- the growth curve of Saccharomyces cerevisiae AMCC31248 is shown in FIG. 3 . It can be seen that the strain grows rapidly in the wort extract medium.
- the growth efficiency of the parent strain and the Saccharomyces cerevisiae AMCC31248 strain is shown in Table 3 below. Table 3 Growth efficiency data of parent and new strains Strain name Growth efficiency AMCC30010 0.013 AMCC32101 0.017 AMCC31248 0.028
- the Saccharomyces cerevisiae AMCC31248 obtained in Example 1 was inoculated into a shake flask containing a fermentation medium and cultured at 30°C.
- the precipitate collected after centrifugation, i.e. the yeast milk, was weighed and the water content of the yeast milk was determined.
- the dough was prepared to test the fermentation activity of the Saccharomyces cerevisiae AMCC31248 strain, the mass of yeast milk of Saccharomyces cerevisiae AMCC31248 strain and parent strains Saccharomyces cerevisiae AMCC30010 and Saccharomyces cerevisiae AMCC32101 required to be added was calculated and weighed, respectively; according to the dough formulation shown, flour, salt, and water were weighed respectively, and mixed in a dough kneader to prepare the dough; an SJA fermenter was used to directly determine the total volume of carbon dioxide gas produced by yeast fermentation of 280 g dough prepared by the system shown in Table 4 at 30°C for 1 h, i.e. the fermentation activity of the strain, and the results were expressed in milliliters (mL).
- Table 4 0% Sugar Dough System Raw material Flour/g Salt/g Water/g Dry yeast/g Addition amount 280 4 144 2.8
- the net dry weight of the Saccharomyces cerevisiae AMCC31248 strain was 95.7% and 109.9% of that of parent strains Saccharomyces cerevisiae AMCC30010 and Saccharomyces cerevisiae AMCC32101, respectively.
- the 0% sugar dough fermentation activity of the Saccharomyces cerevisiae AMCC31248 strain was superior to both parent strains, with an advantage of about 10%.
- Table 5 Net dry weight data of parent and new strains Strain name Net dry weight/(g/L) Relative percentage % Relative percentage % AMCC30010 13.37 100.0 114.8 AMCC32101 11.65 87.1 100.0 AMCC31248 12.80 95.7 109.9
- Table 6 Fermentation activity data of fresh yeast in 0% sugar dough system Strain name 0% sugar 1 h activity/mL Relative percentage % Relative percentage % AMCC30010 1050 100.0 103.1 AMCC32101 1018 97.0 100.0 AMCC31248 1145 109.0 112.5
- the strain AMCC31248 of Saccharomyces cerevisiae was activated and cultured in a 45 L fermenter. Then the activated dry yeast was isolated, washed, filtered, and dried. Flour, salt, water, and prepared active dry yeast were respectively weighed according to the dough formulation shown in Table 7, and the total amount of carbon dioxide gas produced by fermenting 280 g of the dough prepared by the system shown in Table 7 for 1 h by the active dry yeast was assayed using the SJA method, i.e. the dough fermentation activity of the active dry yeast.
- Table 7 0% Sugar dough system Raw material Flour/g Salt/g Water/g Dry yeast/g Addition amount 280 4 144 2.8
- the relative percentage of fermentation activity (fermentation activity of hybrid new strain/fermentation activity of parent strain AMCC 30010) * 100% Table 8 Fermentation activity data of active dry yeast in 0% sugar dough system Strain name 0% sugar 1 h activity/mL Relative percentage of fermentation activity/% AMCC30010 1016 100.0 AMCC31248 1133 111.5
- Saccharomyces cerevisiae AMCC30010 strain the Saccharomyces cerevisiae AMCC31248 strain still had an 11.5% advantage in dough fermentation activity under the condition of 0% sugar, indicating that Saccharomyces cerevisiae AMCC31248 strain had certain resistance to drying.
- the fermentation time of the dough corresponding to the strain of Saccharomyces cerevisiae AMCC31248 and the parent strain of Saccharomyces cerevisiae AMCC30010 is shown in Table 10.
- the relative percentage of fermentation time (fermentation time of hybrid new strain/fermentation time of parent strain AMCC30010) * 100% Table 10 Fermentation time data of active dry yeast in cold osmotic shock dough system Strain name Fermentation time/min Relative percentage of fermentation time/% AMCC30010 154.3 100.0 AMCC31248 108.0 70.0
Landscapes
- Life Sciences & Earth Sciences (AREA)
- Engineering & Computer Science (AREA)
- Mycology (AREA)
- Health & Medical Sciences (AREA)
- Chemical & Material Sciences (AREA)
- Zoology (AREA)
- Genetics & Genomics (AREA)
- Organic Chemistry (AREA)
- Biotechnology (AREA)
- Wood Science & Technology (AREA)
- Microbiology (AREA)
- Bioinformatics & Cheminformatics (AREA)
- General Health & Medical Sciences (AREA)
- Food Science & Technology (AREA)
- Medicinal Chemistry (AREA)
- Biomedical Technology (AREA)
- Virology (AREA)
- Tropical Medicine & Parasitology (AREA)
- Biochemistry (AREA)
- General Engineering & Computer Science (AREA)
- Botany (AREA)
- Nutrition Science (AREA)
- Bakery Products And Manufacturing Methods Therefor (AREA)
- Micro-Organisms Or Cultivation Processes Thereof (AREA)
Applications Claiming Priority (2)
| Application Number | Priority Date | Filing Date | Title |
|---|---|---|---|
| CN202210592367.1A CN117165460B (zh) | 2022-05-27 | 2022-05-27 | 一种快发无糖面用酵母菌株及应用 |
| PCT/CN2023/079577 WO2023226509A1 (zh) | 2022-05-27 | 2023-03-03 | 一种快发无糖面用酵母菌株及应用 |
Publications (2)
| Publication Number | Publication Date |
|---|---|
| EP4530342A1 true EP4530342A1 (de) | 2025-04-02 |
| EP4530342A4 EP4530342A4 (de) | 2025-10-29 |
Family
ID=88918332
Family Applications (1)
| Application Number | Title | Priority Date | Filing Date |
|---|---|---|---|
| EP23810585.2A Pending EP4530342A4 (de) | 2022-05-27 | 2023-03-03 | Hefestamm für schnellfermentierenden zuckerfreien teig und verwendung davon |
Country Status (6)
| Country | Link |
|---|---|
| US (1) | US20250331524A1 (de) |
| EP (1) | EP4530342A4 (de) |
| JP (1) | JP2025518092A (de) |
| KR (1) | KR20250010682A (de) |
| CN (1) | CN117165460B (de) |
| WO (1) | WO2023226509A1 (de) |
Families Citing this family (1)
| Publication number | Priority date | Publication date | Assignee | Title |
|---|---|---|---|---|
| CN120682956A (zh) * | 2024-03-21 | 2025-09-23 | 安琪酵母股份有限公司 | 酿酒酵母菌株、筛选方法和其应用 |
Family Cites Families (20)
| Publication number | Priority date | Publication date | Assignee | Title |
|---|---|---|---|---|
| JPH02238876A (ja) * | 1989-03-14 | 1990-09-21 | Natl Food Res Inst | 新規パン酵母 |
| JPH0771444B2 (ja) * | 1989-03-14 | 1995-08-02 | 農林水産省食品総合研究所長 | 冷凍パン生地 |
| JP2943041B2 (ja) * | 1994-02-02 | 1999-08-30 | 日本甜菜製糖株式会社 | 低温感受性パン酵母及びパン製造法 |
| JP4268355B2 (ja) * | 2000-10-02 | 2009-05-27 | 株式会社カネカ | 乾燥耐性酵母 |
| US20040022897A1 (en) * | 2000-10-02 | 2004-02-05 | Toshiaki Katsumi | Drying-resistant yeast |
| FR2920157B1 (fr) * | 2007-08-23 | 2009-10-16 | Lesaffre Et Cie Sa | Nouvelles souches de levure de panification |
| JP5285987B2 (ja) * | 2008-07-23 | 2013-09-11 | キリン協和フーズ株式会社 | パン酵母 |
| CN101418265B (zh) * | 2008-12-08 | 2011-11-23 | 安琪酵母(伊犁)有限公司 | 耐防腐剂面包酵母菌种及面包酵母的制备方法 |
| CN102018012B (zh) * | 2009-09-18 | 2012-08-29 | 安琪酵母股份有限公司 | 干酵母组合物及其制作方法 |
| JP5907161B2 (ja) * | 2011-03-18 | 2016-04-20 | 株式会社カネカ | 新規パン酵母 |
| CN103210969B (zh) * | 2012-01-19 | 2015-04-08 | 安琪酵母股份有限公司 | 改善馒头风味的复合酵母、制备方法及由其发酵的馒头 |
| FR2991340B1 (fr) * | 2012-06-01 | 2016-02-19 | Lesaffre & Cie | Procede d'obtention de souches de levure ameliorees par modification genetique et croisement |
| CN103275881B (zh) * | 2013-04-27 | 2015-01-28 | 天津科技大学 | 一种适合于冷冻面团发酵的耐冷冻活性干酵母 |
| FR3014900B1 (fr) * | 2013-12-16 | 2017-10-27 | Lesaffre & Cie | Nouvelles souches de levure de panification performantes sur pates non sucrees ou legerement sucrees |
| CN104073449B (zh) * | 2014-07-14 | 2016-08-24 | 天津科技大学 | 一株适合不加糖面团发酵的面包酵母及其选育方法 |
| WO2017178879A1 (en) * | 2016-04-12 | 2017-10-19 | Nextferm Technologies Ltd. | Freeze-resistant yeast and uses thereof |
| JP6927471B2 (ja) * | 2017-04-27 | 2021-09-01 | 国立大学法人帯広畜産大学 | パン酵母、パンの製造方法、パン生地及びパン |
| CN110358693B (zh) * | 2019-07-26 | 2022-02-22 | 海南大学 | 一株适于冷冻面团发酵的高耐性酵母菌株及其应用 |
| CN113355251B (zh) * | 2021-07-28 | 2022-10-04 | 安琪酵母股份有限公司 | 一种耐冷冻酿酒酵母菌株及其应用 |
| CN117165456A (zh) * | 2022-05-27 | 2023-12-05 | 安琪酵母股份有限公司 | 酿酒酵母菌株、筛选方法及其应用 |
-
2022
- 2022-05-27 CN CN202210592367.1A patent/CN117165460B/zh active Active
-
2023
- 2023-03-03 KR KR1020247041578A patent/KR20250010682A/ko active Pending
- 2023-03-03 US US18/870,073 patent/US20250331524A1/en active Pending
- 2023-03-03 WO PCT/CN2023/079577 patent/WO2023226509A1/zh not_active Ceased
- 2023-03-03 EP EP23810585.2A patent/EP4530342A4/de active Pending
- 2023-03-03 JP JP2024569755A patent/JP2025518092A/ja active Pending
Also Published As
| Publication number | Publication date |
|---|---|
| WO2023226509A1 (zh) | 2023-11-30 |
| CN117165460A (zh) | 2023-12-05 |
| US20250331524A1 (en) | 2025-10-30 |
| JP2025518092A (ja) | 2025-06-12 |
| KR20250010682A (ko) | 2025-01-21 |
| CN117165460B (zh) | 2025-08-05 |
| EP4530342A4 (de) | 2025-10-29 |
Similar Documents
| Publication | Publication Date | Title |
|---|---|---|
| US4693898A (en) | Novel baker's yeast and process for making bread | |
| EP4502138A1 (de) | Saccharomyces cerevisiae stamm, verfahren zu seiner untersuchung und verwendung davon | |
| CN117165455B (zh) | 一种耐高糖渗透酿酒酵母菌株及应用 | |
| EP4530342A1 (de) | Hefestamm für schnellfermentierenden zuckerfreien teig und verwendung davon | |
| Kasegn et al. | Characterization of wild yeasts isolated from cereal sourdoughs and their potential for leavening wheat dough | |
| FI97068B (fi) | Uusi leivinhiiva | |
| CN117229930B (zh) | 一种酵母菌、酵母菌粉及其在面食加工中的应用 | |
| EP4715039A1 (de) | Kluyveromyces marxianus stamm und verwendung davon | |
| Qureshi et al. | Isolation and taxonomic characterization of yeast strains on the basis of maltose utilization capacity for bread making | |
| JPH0779767A (ja) | 新規酵母及び該酵母を含有するパン生地 | |
| JP5285987B2 (ja) | パン酵母 | |
| CN104357342A (zh) | 一种新疆地方特色馕面团优质酵母及其在制馕中的应用 | |
| SU975798A1 (ru) | Штамм дрожжей SасснаRомYсеS ceReVISIae раса с-2,N6,используемый дл сбраживани квасного сусла | |
| CN120682955A (zh) | 耐重糖酿酒酵母菌株、筛选方法及其应用 | |
| WO2025195016A1 (zh) | 酿酒酵母菌株、筛选方法和其应用 | |
| JP2003164252A (ja) | パン酵母及びその製造方法 | |
| CN117586910B (zh) | 一株植物乳杆菌lwq17及其应用 | |
| Azmuda et al. | Production and comparison of indigenous and commercial baker’s yeasts | |
| JP2013172739A (ja) | パン酵母 | |
| CN119432628A (zh) | 一种耐高糖高发酵力的酿酒酵母菌及其应用 | |
| Tadayon | Characteristics of Yeasts Isolated From Bread Doughs of Bakeries in Shiraz, Iran | |
| Sugihara | Commercial starters in the United States | |
| JP2003047391A (ja) | 乾燥耐性酵母 | |
| Umeh et al. | Yeast Strains from Burukutu and Fura, as an Alternative for Commercial Baker’s Yeast | |
| KR20250113737A (ko) | 신규 효모의 대용량 호기적인 액체배양 스타터에 의한 제과·제빵 방법 |
Legal Events
| Date | Code | Title | Description |
|---|---|---|---|
| STAA | Information on the status of an ep patent application or granted ep patent |
Free format text: STATUS: THE INTERNATIONAL PUBLICATION HAS BEEN MADE |
|
| PUAI | Public reference made under article 153(3) epc to a published international application that has entered the european phase |
Free format text: ORIGINAL CODE: 0009012 |
|
| STAA | Information on the status of an ep patent application or granted ep patent |
Free format text: STATUS: REQUEST FOR EXAMINATION WAS MADE |
|
| 17P | Request for examination filed |
Effective date: 20241224 |
|
| AK | Designated contracting states |
Kind code of ref document: A1 Designated state(s): AL AT BE BG CH CY CZ DE DK EE ES FI FR GB GR HR HU IE IS IT LI LT LU LV MC ME MK MT NL NO PL PT RO RS SE SI SK SM TR |
|
| DAV | Request for validation of the european patent (deleted) | ||
| DAX | Request for extension of the european patent (deleted) | ||
| A4 | Supplementary search report drawn up and despatched |
Effective date: 20250930 |
|
| RIC1 | Information provided on ipc code assigned before grant |
Ipc: C12N 1/18 20060101AFI20250924BHEP Ipc: A21D 8/04 20060101ALI20250924BHEP Ipc: C12R 1/865 20060101ALI20250924BHEP |